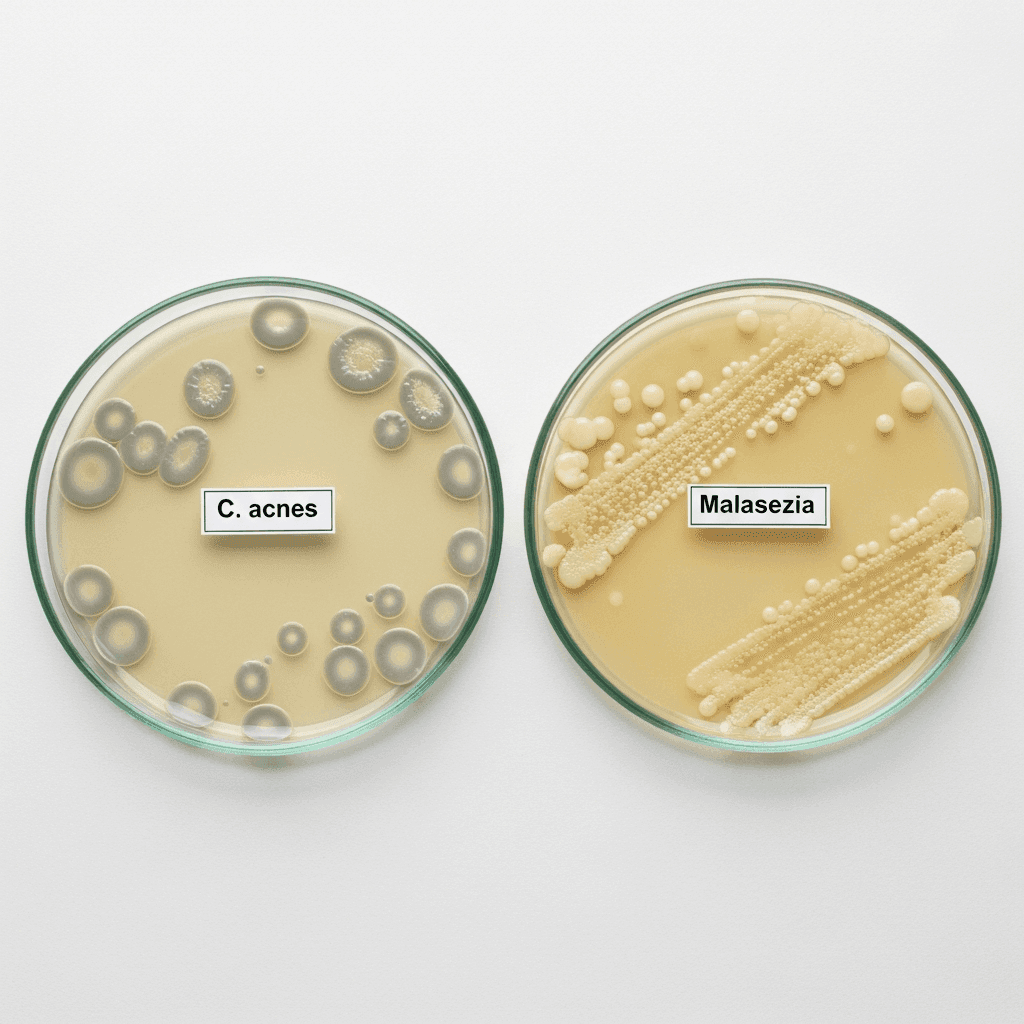
Fungal Acne vs. Regular Acne: How to Identify and Treat It

Welcome to Kiana's Skin Diary
Explore skincare topics based on science. Find the perfect routine and products for your skin type.
Discover Our Interactive Skincare Tools
Go beyond the articles. Use our free tools to get personalized advice and build a smarter routine in seconds.
Body Care
Your skincare routine shouldn't stop at your neck. This is your complete guide to healthy, radiant skin from head to toe. Discover the best body lotions, sunscreens, and targeted treatments for concerns like Keratosis Pilaris ("strawberry skin"), dryness, and body acne.

The 5 Best Body Lotions for Dry, Itchy, and Sensitive Skin
I have dry skin—I mean, reallydry. Growing up in a dry climate, I spent my life experimenting with countless body lotions, and Ican tell you from experience: most just provide a temporary fix. It wasn't until I understood the science of barrier repair—the essential role of Ceramides, occlusives, and humectants—that I found body lotions that provided lasting relief.

What is "Strawberry Skin" (Keratosis Pilaris) and How to Treat It
I remember the first time I felt self-conscious in a swimsuit. It wasn't about being overweight; it was those persistent, bumpy patches on my arms and legs. They're totally harmless, but they made me feel like something was wrong with my skin. Learning that they were Keratosis Pilaris (KP) was the first step. This is my guide to understanding what it is and, more importantly, the simple routine that finally made my skin feel smooth and confident.
Product Reviews
Confused by the endless options in the skincare aisle? Our honest, in-depth product reviews are here to help. We cut through the marketing hype to give you science-backed analysis of the most popular and effective products on the market, so you can shop with confidence.

Do You Really Need an Eye Cream? The Honest Truth
I’ve spent years navigating the confusing world of eye creams, and I can tell you one thing: the marketing can be utterly baffling. The reality is this: do you reallyneed a separate product for your eyes? The answer, surprisingly, isn't always yes. This guide is about knowing the truth—when an eye cream is worth the investment and, equally important, when it's just a waste of money.

Is Drunk Elephant's Protini Serum Worth the Hype? An Honest Review
I’ve spent years obsessing over the science of anti-aging skincare, so when I finally bit the bullet and bought Drunk Elephant’s Protini Polypeptide Cream, I had high expectations. This isn't just a review; this is a deep dive. Ibreak down the ingredients, test their claims, and tell you—honestly—whether this cult-favorite moisturizer is truly worth the price tag.

CeraVe vs. La Roche-Posay: Which Drugstore Brand is Right for You?
The drugstore aisle is a battleground of great skincare. And for years, I was torn between the simple, reliable blue and white of CeraVe and the chic, dermatologist-beloved French pharmacy aesthetic of La Roche-Posay. I've used both brands extensively. The key to choosing is understanding their distinct strengths. This is my head-to-head breakdown, helping you decide which brand is the winner for yourskin type and goals.

The Ordinary: The 5 Best-Selling Products Actually Worth Your Money
My first order from The Ordinary felt like a blind guess. The scientific names were intimidating, and I ended up with a box of little bottles I had no idea how to use. It took months of research and trial-and-error to separate the true heroes from the hype. This is the simple "cheat sheet" I wish I'd had from the very beginning, highlighting the five products that are truly worth your money.
Skincare Ingredients Explained
Your guide to the science behind skincare. We break down the most powerful ingredients, from Retinol to Vitamin C, explaining what they do and how to use them for a smarter, more effective routine.

Niacinamide: The Ultimate Guide to This Multitasking Ingredient
My skin has always been a confusing contradiction: an oily T-zone, but also red, sensitive, and prone to dehydration. For years, I thought I needed a dozen different products to tackle each problem individually. It wasn't until I discovered the "Swiss Army knife" of skincare, Niacinamide, that I found a single ingredient that could calm my redness, control my oil, and strengthen my barrier all at once.

"Skin Purging" vs. "Breaking Out": How to Tell the Difference
The first time Iused a potent Retinoid, my skin erupted in a way I hadn't seen in years. My immediate reaction was panic, thinking the expensive serum was ruining my face. Ialmost threw it in the trash. It wasn't until Ilearned the crucial difference between a "purge" and a bad reaction that I understood the breakout was actually a sign the product was working. This is the guide I wish I'd had during that confusing and stressful week.

Ceramides: The Secret to a Healthy, Resilient Skin Barrier
My worst skincare mistake wasn't a product; it was a philosophy. Iused to believe that attacking my skin with high-strength actives was the key to success, which led to a red, stinging, and painfully compromised skin barrier. It was a miserable experience, but it taught methe most important lesson of all: a strong, healthy barrier isn't a bonus, it's the entire foundation. And the key to rebuilding that foundation? Ceramides.

Azelaic Acid for Acne and Redness: A Beginner's Guide
For years, my battle with acne was a frustrating cycle. Salicylic Acid cleared my blackheads, but did little for my red, angry pimples. Benzoyl Peroxide zapped the pimples, but left my skin dry and irritated. It wasn't until Idiscovered Azelaic Acid that I finally found an ingredient that could do both: calm the furious inflammation andclear the breakout. This is my guide to the gentle powerhouse that brought peace to my perpetually angry skin.
Anti-Aging & Serums
Discover the science behind youthful skin. Explore expert tips, ingredient guides, and product recommendations focused on anti-aging treatments and serums that help reduce wrinkles, boost collagen, and restore a radiant complexion.

Peptides for Skin: The Ultimate Guide to a Firmer Complexion
I had my routine dialed in: Vitamin C in the morning, Retinoids at night. I thought I had all the anti-aging bases covered. But I felt like a crucial piece was missing. My routine had a "protector" and a "trainer," but who were the "builders"? My deep dive into the science led me to Peptides, the unsung heroes that work to rebuild your skin's foundational structure from within. This is the guide to the ingredient that completed my anti-aging trifecta.

The 5 Best Anti-Aging Serums of 2025: Picks That Actually Work
For a long time, I thought "anti-aging" was just clever marketing. Then the fine lines around my eyes stopped disappearing after I smiled. I dove into clinical studies and dermatological research to separate the science from the sales pitches. This isn't just another list of serums; this is my strategic guide to the powerhouse ingredients that are scientifically proven to work, and the specific products I've personally vetted and spent my own money on.
Routines
beginner skincare, skincare routine, glowing skin, self care

How to Repair a Damaged Skin Barrier: 5 Signs & A Simple Fix (2025)
My worst skincare mistake wasn't a product; it was a philosophy. I used to believe that attacking my skin with high-strength actives was the key to success, which led to a red, stinging, and painfully compromised skin barrier. It was a miserable experience, but it taught me the most important lesson of all: a strong, healthy barrier isn't a bonus, it's the entire foundation. This is my personal guide to rebuilding that foundation.

How to Combine Active Ingredients: A Simple Guide to Layering Vitamin C, Retinol, and Acids
My bathroom cabinet used to be the scene of a chemistry experiment gone wrong. Convinced that more actives meant better skin, Ilayered my powerful Retinoid and my Glycolic Acid on the same night. The result? A red, stinging, irritated disaster. That painful mistake taught methe most important rule of skincare: great ingredients require a great strategy, or you're just starting a war with your own face.

How to Find Your Skin Type: A Simple Guide and At-Home Test
For the longest time, I was convinced I had oily skin. I spent years attacking it with harsh cleansers and clay masks, wondering why my cheeks still felt tight and my T-zone was a greasy mess. The truth? I actually have combination skin that was severely dehydrated. Figuring this out with a simple, at-home test was the single biggest breakthrough in my entire skincare journey. This is the guide to finally stop guessing.

What is Skin Cycling? A Beginner's Guide to the 4-Night Routine
I used to be a "more is more" person with my skincare. I had my powerful Retinoid and my Glycolic Acid, and I tried to use them both as often as possible, thinking I'd get faster results. The result? A constantly irritated, compromised skin barrier. Skin cycling, a 4-night schedule developed by a dermatologist, was the strategic "aha!" moment that taught me the most important lesson in skincare: recovery is just as important as the treatment itself.

The Ultimate Beginner's Skincare Routine (A Simple 3-Step Guide)
I fell into the 10-step routine trap. I bought all the trendy serums and harsh exfoliants I saw online, and my skin had never been worse. It took stripping everything away and going back to these three simple, foundational steps to finally heal my skin barrier. This isn't just a beginner's guide; it's the most important lesson I've ever learned in skincare.
Acne & Blemishes
Your complete guide to understanding and treating acne. From identifying different types of pimples to finding the right ingredients, we break down the science of clear skin.

How to Fade Acne Scars and Dark Marks: A Complete Guide
The active pimple was gone, but its ghost remained—a stubborn red mark on my cheek that lasted for months. I was winning the battles against breakouts but losing the war for clear skin. It wasn't until I learned the crucial difference between the red marks (PIE) and the brown marks (PIH) that I could finally create a targeted strategy to erase the evidence and reclaim my even skin tone.

Fungal Acne vs. Regular Acne: How to Identify and Treat It
For over a year, my forehead was a battlefield of tiny, stubborn, itchy bumps that no acne product could defeat. Itried Salicylic Acid, Benzoyl Peroxide, even my trusted Retinoid, and nothing worked. It wasn't until a desperate late-night research session that I discovered the shocking truth: I wasn't fighting acne at all. I was fighting a fungus.

How to Get Rid of Blackheads on Your Nose: A Dermatologist-Approved Guide
My war against the blackheads on my nose was long and brutal. I was a serial squeezer and a pore strip addict, convinced I could physically rip the problem out of my skin. All I got was a red, irritated nose and pores that looked even bigger. It wasn't until I learned the science of what a blackhead reallyis that Ifinally won the war—not with force, but with chemistry.

7 Common Habits That Are Secretly Causing Your Breakouts
I was doing everything right. My skincare routine was packed with the best ingredients, from Salicylic Acid to Retinoids. Yet, I was still getting these frustrating, random breakouts. It wasn't until I stopped looking at my products and started looking at my habitsthat I finally solved the mystery. This guide is about the 7 surprising culprits I discovered that were secretly sabotaging all my hard work.

Salicylic Acid: Your Ultimate Guide to Unclogging Pores
I used to attack the blackheads on my nose with harsh scrubs and pore strips, thinking I could physically force them out. It was a disaster that left me red and irritated, with the same clogged pores returning days later. It wasn't until I understood the science of whythose methods fail that I discovered Salicylic Acid. This isn't just an ingredient; for me, it was the key that finally unlocked my pores.

The Science of Acne: A Complete Guide to Why You Break Out
I thought my acne was just about bacteria, so I nuked my face with harsh treatments and got nowhere. It wasn't until I truly understood the fullstory—the four-part chain reaction happening under my skin—that I could finally stop fighting a losing battle. This isn't just a science lesson; this is the crucial knowledge that transformed me from a frustrated victim of my breakouts into an empowered skin detective.

The Ultimate Guide to Preventing Acne and Blemishes in 2025
I spent most of my adult life in a frustrating cycle: breakout, attack with harsh products, get dry and irritated skin, and then break out again. It was exhausting. It wasn't until I stopped fighting a war againstmy skin and started working withit that I finally saw lasting results. This guide isn't just about ingredients; it's the strategic, balanced approach I learned to finally achieve and maintain clear skin.
Cleansers & Toners
The foundation of every great skincare routine begins here. Discover our expert guides on choosing the right cleanser for your skin type and learn how toners can balance, hydrate, and prep your skin for the rest of your routine.

What is Double Cleansing? A Beginner's Guide to Truly Clean Skin
For years, I thought I was a "good" cleanser. I washed my face diligently every night, but my skin still felt congested, and I’d always see a faint trace of makeup on my cotton pad. Then I learned about the double cleansing method. This isn't just another skincare trend; it’s the secret to truly clean skin, and it transformed my routine. This is my guide to mastering the technique.

How to Layer Your Skincare: The Perfect Nighttime Routine
I used to be a "skincare cocktail" enthusiast. If an ingredient was good, I figured more was better, so I layered my Retinol, Glycolic Acid, and other serums all at once. The result? A red, stinging, irritated mess. It was a painful lesson, but it taught me the most crucial rule of skincare: howyou apply your products is just as important as whatyou apply. This is the simple, logical framework that saved my skin.

How to Build The Perfect Morning Skincare Routine: A 4-Step Guide
I used to think of my morning and evening skincare routines as basically the same, just with different products. This was my first mistake. The truth is, they have completely different job descriptions. Your nighttime routine is for Repair and Correction. It’s when you use powerful ingredients like Retinoids and exfoliating acids to renovate your skin while you sleep.

How to Choose the Right Cleanser and Toner for Your Skin Type
I spent years using the wrong cleanser, thinking that a "squeaky clean" feel meant it was working. I was wrong. That tightness was actually my skin barrier crying for help. This guide isn't just a list of products; it's the lesson I learned the hard way on how to choose the right foundational tools for your routine. Let me save you the time, money, and irritation I went through.
Sunscreen
Sun protection is the most powerful anti-aging tool in your arsenal.

Why Body Sunscreen is Your Most Important Daily Accessory
I spent years perfecting my facial skincare, treating my face like a precious jewel. Then one day, I caught my reflection and was horrified to see a distinct patch of sunspots on my chest and that the skin on my "driving arm" looked years older than the other. My face was protected, but I was completely neglecting the rest of my skin. That was the day body sunscreen stopped being a beach-day chore and became my most essential daily accessory.

The 5 Best Sunscreens for Oily & Acne-Prone Skin (Tested 2025)
I spent years in a vicious cycle: wear sunscreen, feel like a greaseball, get a breakout, and then become terrified to wear sunscreen again. The struggle is real. But after an obsessive search and testing dozens of formulas, I can confidently say that sunscreens you'll actually loveto wear exist. This is my battle-tested list of the ones that finally ended the war.

Sunscreen 101: The Ultimate Guide to Choosing and Applying SPF
I get asked all the time: "If you could only use one skincare product for the rest of your life, what would it be?" My answer is always the same, and it's not a fancy serum. It's sunscreen. I used to think of SPF as a sticky, unpleasant chore for beach days. It wasn't until I truly understood what UV rays were doing to my skin on a daily basis—even on cloudy days, even through windows—that it became the most important and non-negotiable step in my entire routine.
Serums
Discover powerful, targeted solutions for your skin concerns.

Glycolic Acid: Your Ultimate Guide to Brighter, Smoother Skin
I'll be honest: my first experience with Glycolic Acid was a disaster. I bought a high-strength serum, used it way too often, and ended up with a red, stinging, and compromised skin barrier. I almost wrote off the ingredient forever. It wasn't until I learned to respect its power and use it strategically that I unlocked its incredible secret to achieving a smooth, glass-like glow. This is the guide I wish I had before I made all my rookie mistakes.

The Ultimate Guide to Hyaluronic Acid: Get Plump, Hydrated Skin
I used to think Hyaluronic Acid was just overhyped water for people with dry skin. I have oily skin, so I ignored it for years. When I finally tried it, I made the #1 mistake: I applied it to dry skin, and it actually made my face feel tighter. This guide is about the crucial lesson I learned that turned this ingredient from a frustrating mystery into the cornerstone of my plump, hydrated skin.

The 5 Best Vitamin C Serums on Amazon (Honest 2025 Review)
I wasted over $50 on my first Vitamin C serum, only to watch it turn orange and useless in my medicine cabinet. I was frustrated and confused. That mistake forced me to dive deep into the science of what actuallymakes a Vitamin C serum effective—from the specific form to the pH and stabilizing ingredients. This guide is the result of that obsessive research, created to save you from making the same costly mistakes I did.

Your Definitive Guide to Fading Dark Spots & Hyperpigmentation (2025)
I'll never forget the cluster of dark purple marks a bad breakout left on my cheek in my mid-20s. The acne was gone, but the ghosts remained. I wasted so much money on "brightening" scrubs and useless masks before I finally learned the truth: fading hyperpigmentation isn't about one magic product. It's a strategic, multi-front war. This guide is the exact, science-backed battle plan I used to finally win.

Dry vs. Dehydrated Skin: Finally Understand the Difference
I have oily, acne-prone skin, so for years I thought "hydration" wasn't for me. I ran from rich creams, convinced they'd clog my pores. Yet my skin looked dull, my fine lines were deepening, and it felt uncomfortably tight. It wasn't until I learned the crucial difference between oil (dryness) and water (dehydration) that I had my biggest skincare breakthrough. This is the lesson that finally taught me how to get plump, glowing skin—without causing breakouts.

Retinol vs. Retinal: Which Vitamin A Is Right for Your Skin?
I used a 1% retinol for over a year and loved the results... until I hit a plateau. My skin was good, but not great. I became obsessed with understanding if there was a next level up without getting a prescription. That's when I dove into the science of Retinal. This guide explains the crucial difference that led me to upgrade, get faster results, and finally tackle my most stubborn texture issues.